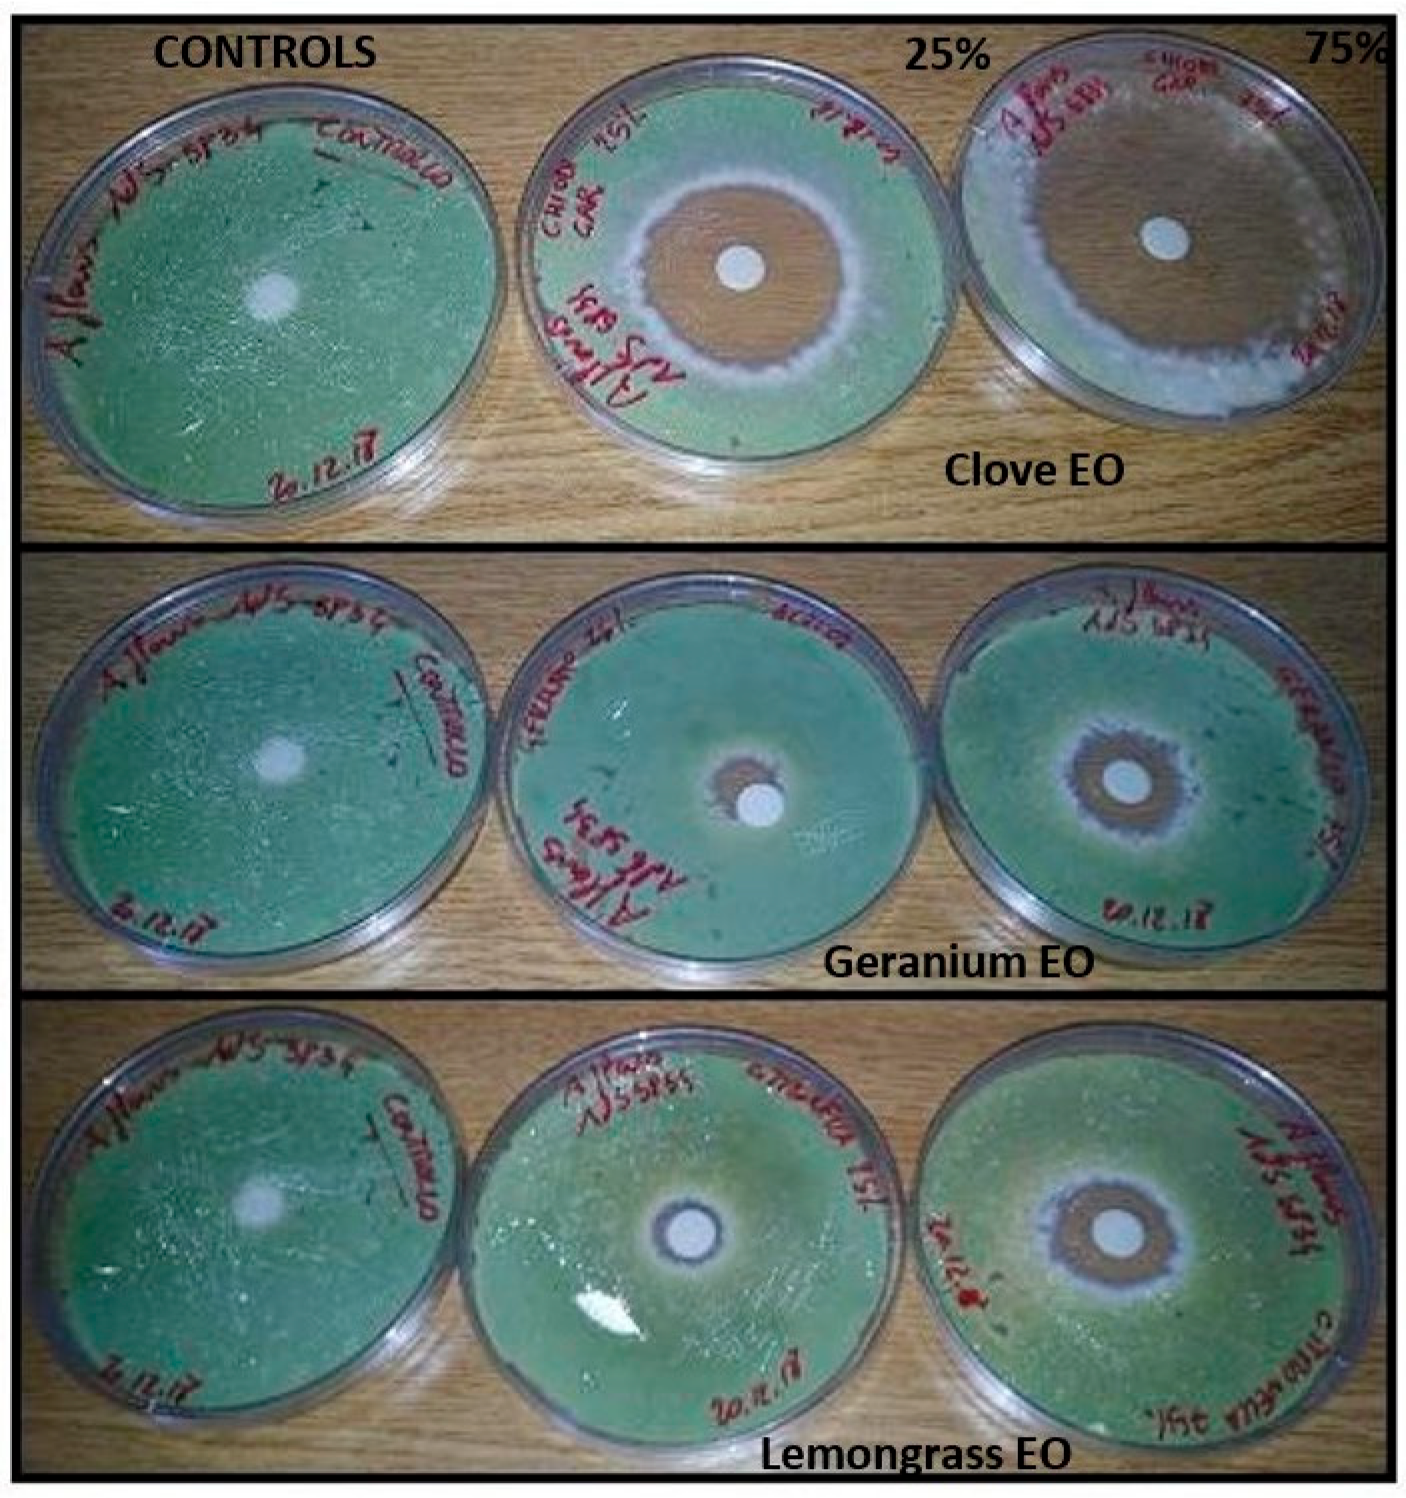
Molecules 28 07259 g001
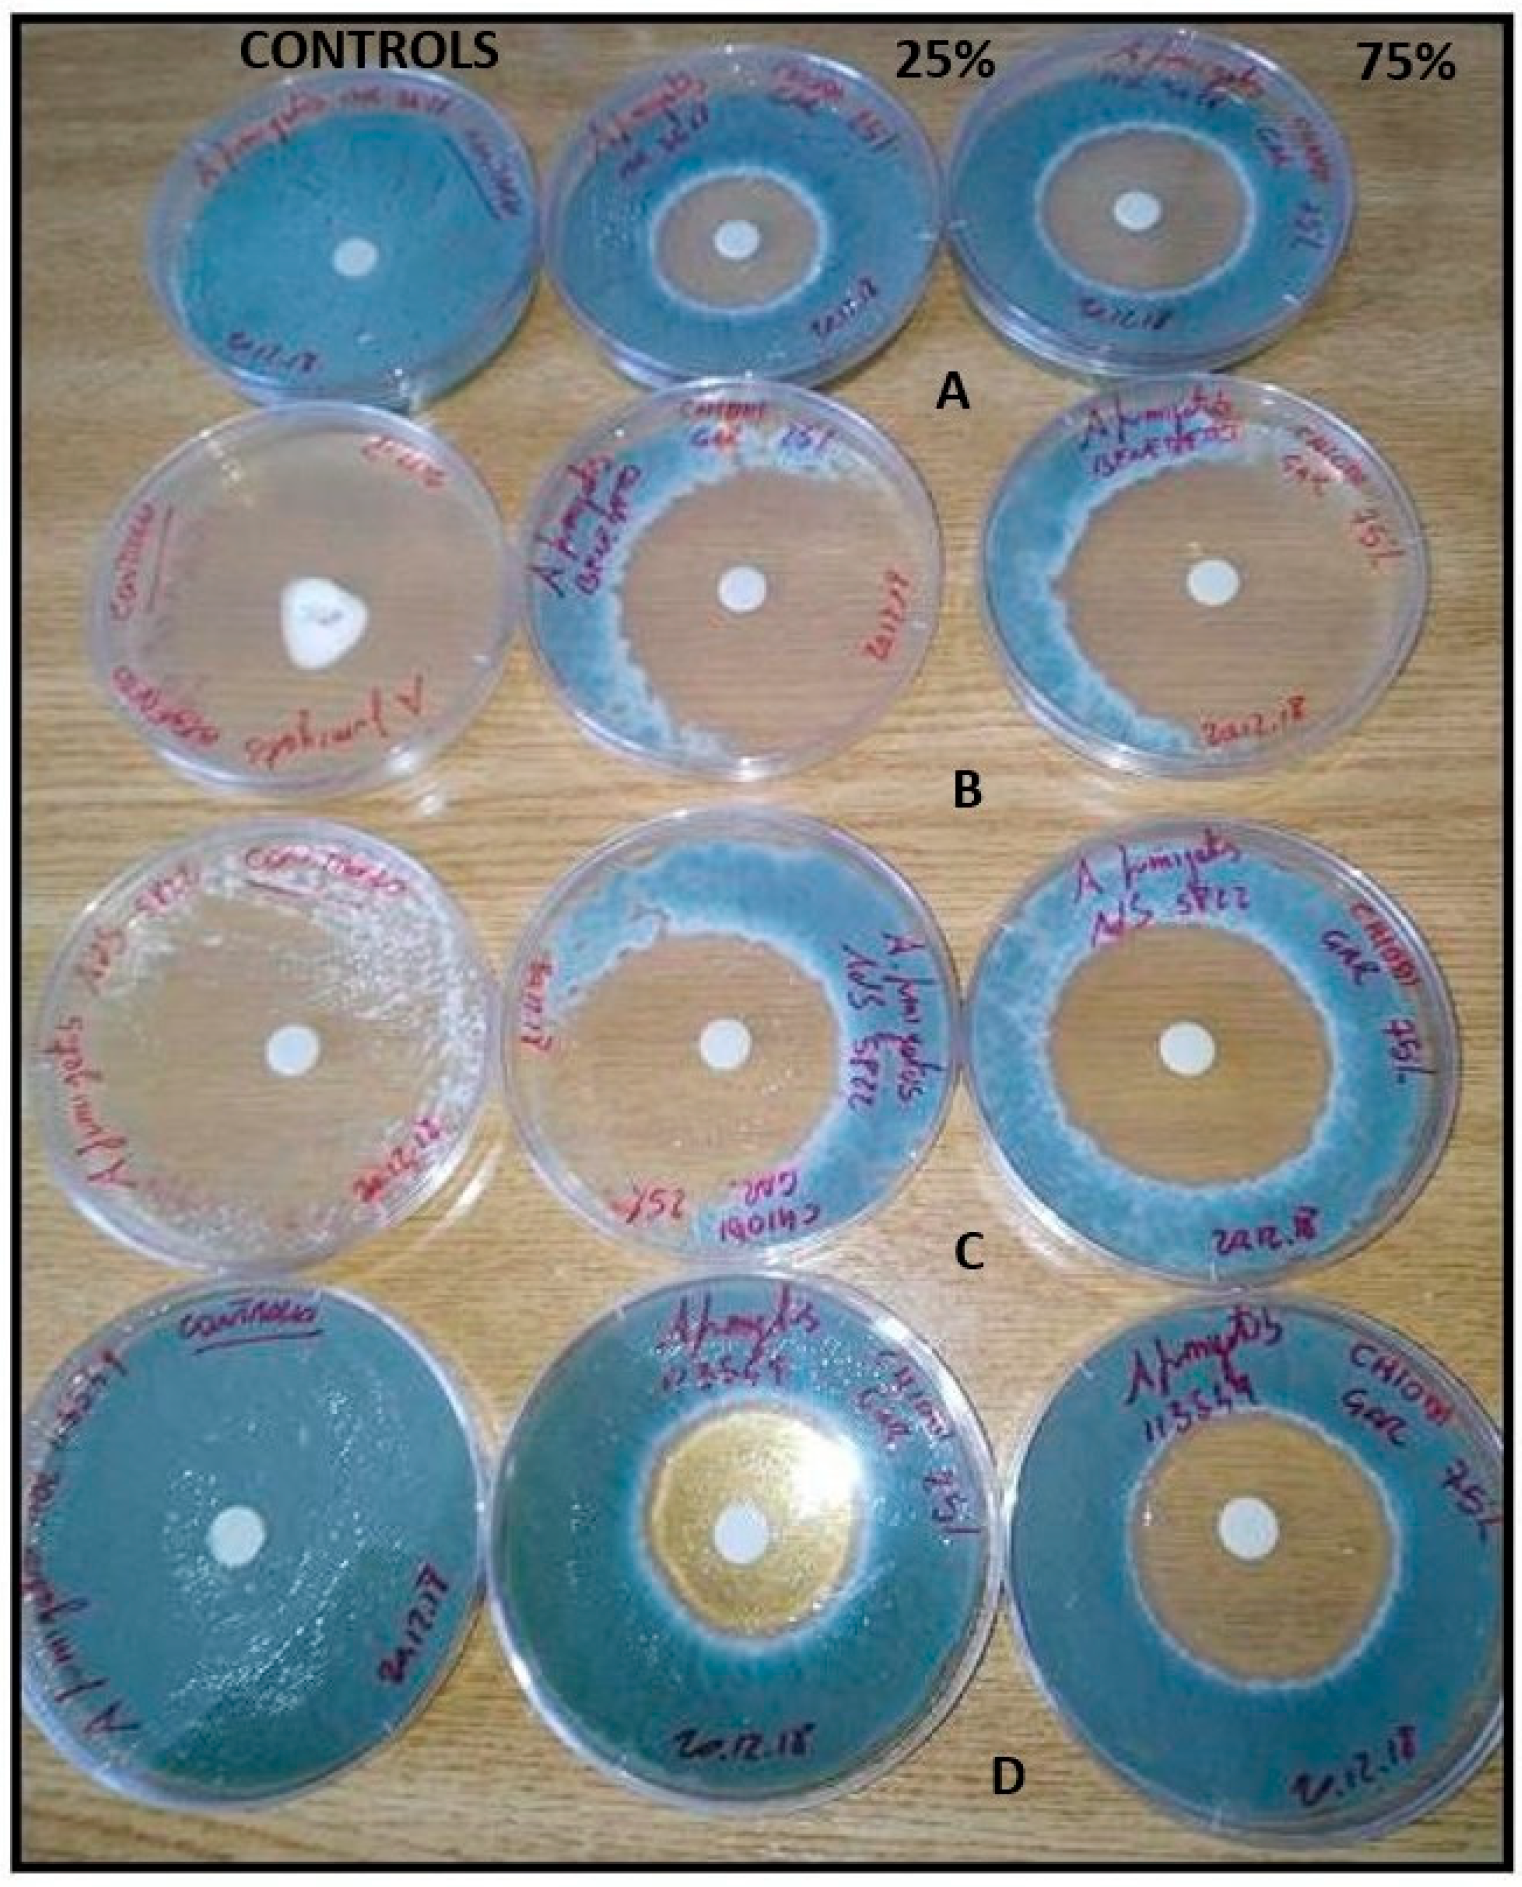
Molecules 28 07259 g002
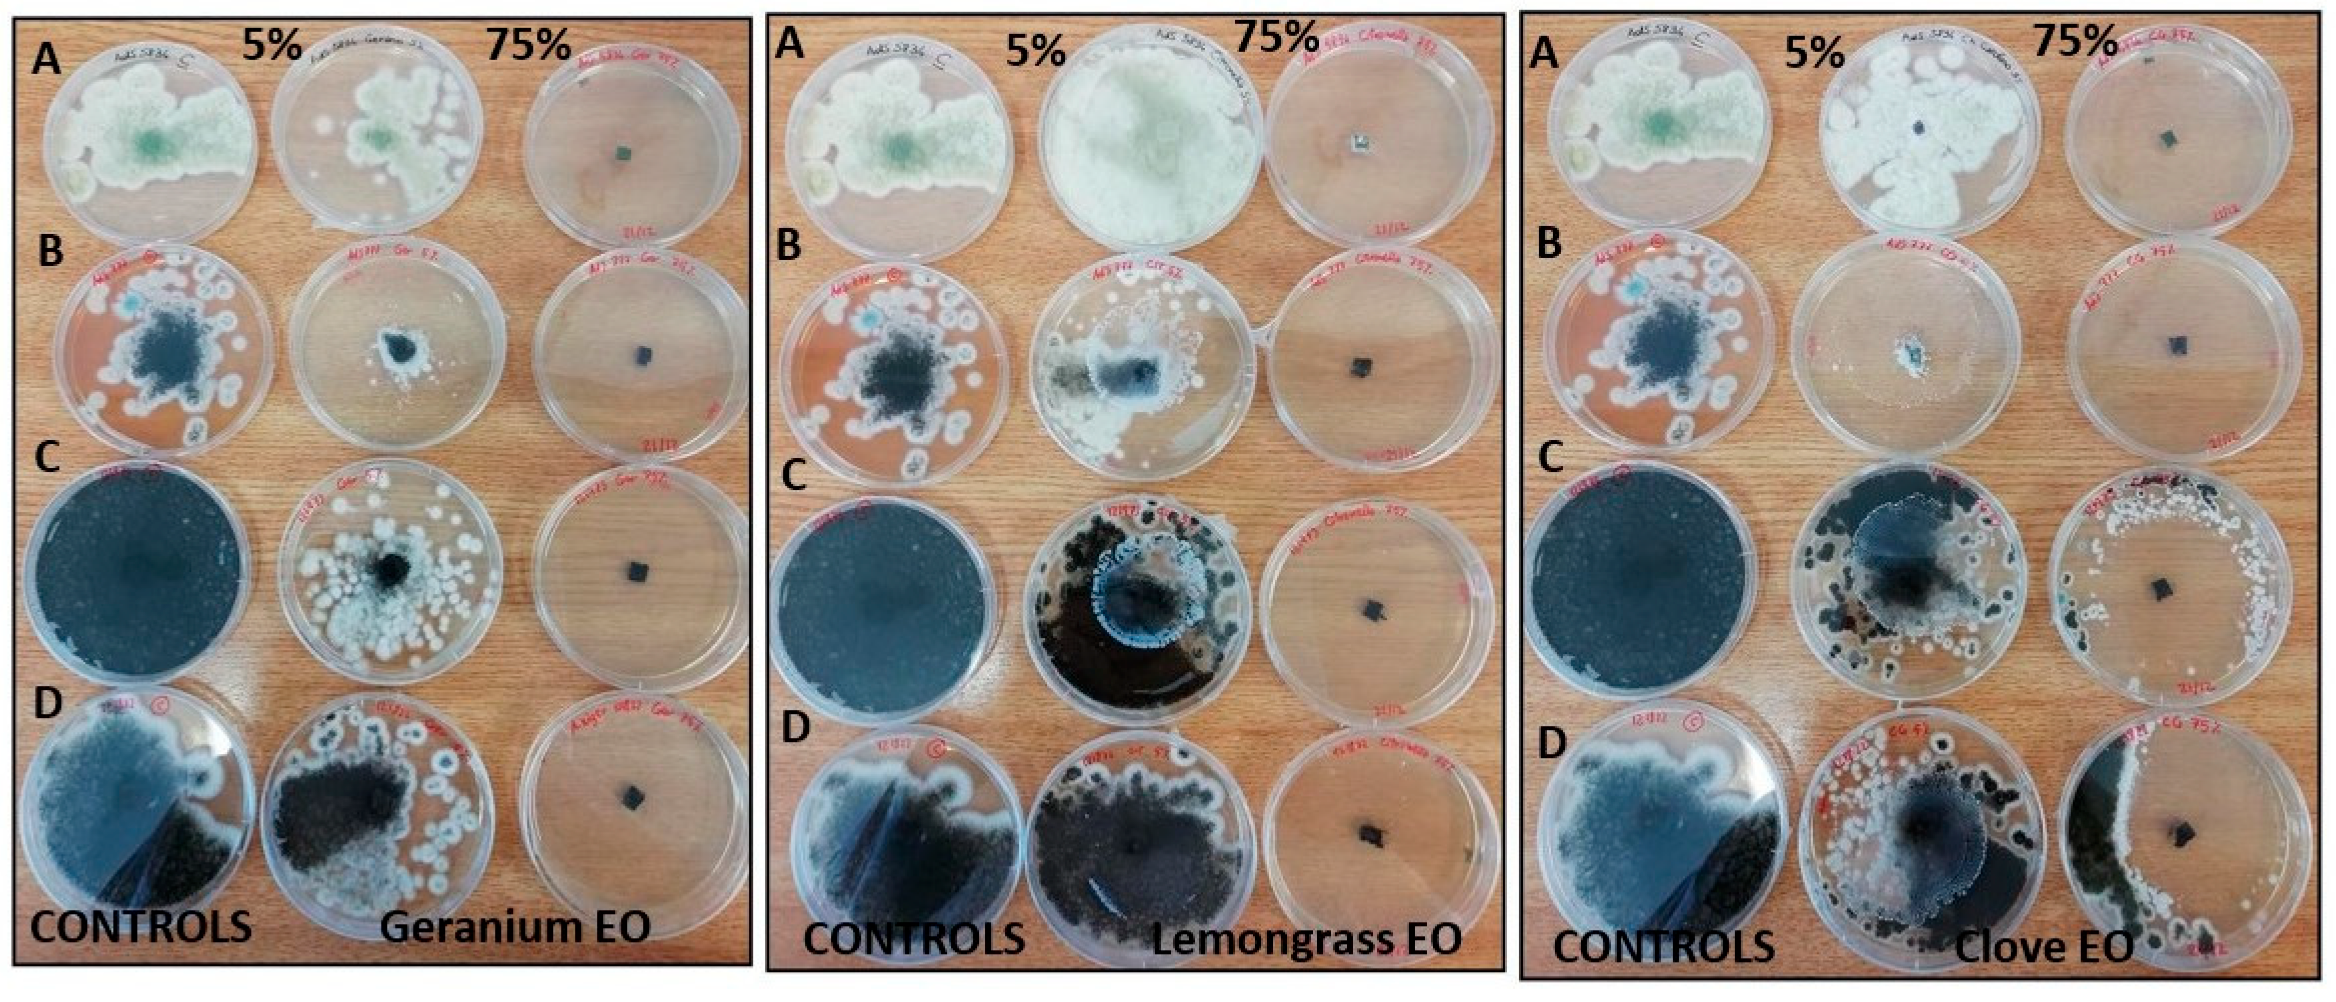
Molecules 28 07259 g006

In Vitro Antifungal Activity of Selected Essential Oils against Drug-Resistant Clinical Aspergillus spp. Strains
Abstract
:1. Introduction
2. Results
2.1. Chemical Component Analysis
2.2. Determination of Antifungal Activity
3. Discussion
4. Material and Methods
4.1. Strains
4.2. Antifungal Agents
4.3. Essential Oils and Their Components
4.4. Inoculum Preparation
4.5. Broth Micro Dilution Method
4.6. Agar Diffusion Technique
4.7. Determination of Fungistatic and Fungicidal Activities
4.8. Vapor Contact Assay
4.9. Data and Statistical Analysis
5. Conclusions
Supplementary Materials
Author Contributions
Funding
Institutional Review Board Statement
Informed Consent Statement
Data Availability Statement
Acknowledgments
Conflicts of Interest
Sample Availability
References
- Thompson, G.R., 3rd; Young, J.H. Aspergillus Infections. N. Engl. J. Med. 2021, 14, 1496–1509. [Google Scholar] [CrossRef] [PubMed]
- Pérez-Cantero, A.; López-Fernández, L.; Guarro, J.; Capilla, J. Azole resistance mechanisms in Aspergillus: Update and recent advances. Int. J. Antimicrob. Agents 2020, 55, 105807. [Google Scholar] [CrossRef] [PubMed]
- Merad, Y.; Derrar, H.; Belmokhtar, Z.; Belkacemi, M. Aspergillus Genus and Its Various Human Superficial and Cutaneous Features. Pathogens 2021, 23, 643. [Google Scholar] [CrossRef]
- Gupta, A.K.; Venkataraman, M.J. Antifungal resistance in superficial mycoses. Dermatol. Treat. 2022, 33, 1888–1895. [Google Scholar] [CrossRef]
- Pawar, V.C.; Thaker, V.S. In vitro efficacy of 75 essential oils against Aspergillus niger. Mycoses 2006, 49, 316–323. [Google Scholar] [CrossRef] [PubMed]
- Horváth, G.; Török Jenei, J.; Vágvölgyi, C.; Böszörményi, A.; Krisch, J. Effects of essential oil combinations on pathogenic yeasts and moulds. Acta Biol. Hung. 2016, 67, 205–214. [Google Scholar] [CrossRef]
- Tullio, V.; Nostro, A.; Mandras, N.; Dugo, P.; Banche, G.; Cannatelli, M.A.; Cuffini, A.M.; Alonzo, V.; Carlone, N.A. Antifungal activity of essential oils against filamentous fungi determined by broth microdilution and vapour contact methods. J. Appl. Microbiol. 2007, 102, 1544–1550. [Google Scholar] [CrossRef] [PubMed]
- Puškárová, A.; Bučková, M.; Kraková, L.; Pangallo, D.; Kozics, K. The antibacterial and antifungal activity of six essential oils and their cyto/genotoxicity to human HEL 12469 cells. Sci. Rep. 2017, 15, 8211. [Google Scholar] [CrossRef]
- Mani-López, E.; Cortés-Zavaleta, O.; López-Malo, A. A review of the methods used to determine the target site or the mechanism of action of essential oils and their components against fungi. SN Appl. Sci. 2021, 3, 44. [Google Scholar] [CrossRef]
- Sakkas, H.; Papadopoulou, C. Antimicrobial Activity of Basil, Oregano, and Thyme Essential Oils. J. Microbiol. Biotechnol. 2017, 27, 429–438. [Google Scholar] [CrossRef]
- Yammine, J.; Chihib, N.E.; Gharsallaoui, A.; Dumas, E.; Ismail, A.; Karam, L. Essential oils and their active components applied as: Free, encapsulated and in hurdle technology to fight microbial contaminations. A review. Heliyon 2022, 20, e12472. [Google Scholar] [CrossRef] [PubMed]
- Swamy, M.K.; Akhtar, M.S.; Sinniah, U.R. Antimicrobial Properties of Plant Essential Oils against Human Pathogens and Their Mode of Action: An Updated Review. Evid. Based Complement. Altern. Med. 2016, 2016, 3012462. [Google Scholar] [CrossRef] [PubMed]
- Bakkali, F.; Averbeck, S.; Averbeck, D.; Idaomar, M. Biological effects of essential oils. Food Chem. Toxicol. 2008, 46, 446–475. [Google Scholar] [CrossRef]
- Sienkiewicz, M.; Głowacka, A.; Kowalczyk, E.; Wiktorowska-Owczarek, A.; Jóźwiak-Bębenista, M.; Łysakowska, M. The biological activities of cinnamon, geranium and lavender essential oils. Molecules 2014, 19, 20929–20940. [Google Scholar] [CrossRef]
- Yassin, Z.; Lotfali, E.; Rafi Khourgami, M.; Omidi, N.; Fattahi, A.; Ahmad Nasrollahi, S.; Ghasemi, R. Caspofungin resistance in clinical Aspergillus flavus isolates. J. Mycol. Med. 2021, 31, 101166. [Google Scholar] [CrossRef] [PubMed]
- Scalas, D.; Mandras, N.; Roana, J.; Tardugno, R.; Cuffini, A.M.; Ghisetti, V.; Benvenuti, S.; Tullio, V. Use of Pinus sylvestris L. (Pinaceae), Origanum vulgare L. (Lamiaceae), and Thymus vulgaris L. (Lamiaceae) essential oils and their main components to enhance itraconazole activity against azole susceptible/not-susceptible Cryptococcus neoformans strains. BMC Complement. Altern. Med. 2018, 18, 43. [Google Scholar] [CrossRef]
- Pinto, E.; Vale-Silva, L.; Cavaleiro, C.; Salgueiro, L. Antifungal activity of the clove essential oil from Syzygium aromaticum on Candida, Aspergillus and dermatophyte species. J. Med. Microbiol. 2009, 58, 1454–1462. [Google Scholar] [CrossRef]
- Mandras, N.; Roana, J.; Scalas, D.; Del Re, S.; Cavallo, L.; Ghisetti, V.; Tullio, V. The Inhibition of Non-albicans Candida Species and Uncommon Yeast Pathogens by Selected Essential Oils and Their Major Compounds. Molecules 2021, 26, 4937. [Google Scholar] [CrossRef]
- Roana, J.; Mandras, N.; Scalas, D.; Campagna, P.; Tullio, V. Antifungal Activity of Melaleuca alternifolia Essential Oil (TTO) and Its Synergy with Itraconazole or Ketoconazole against. Trichophyton rubrum. Molecules 2021, 26, 461. [Google Scholar] [CrossRef]
- Athanassiadis, B.; Abbott, P.V.; George, N.; Walsh, L.J. An in vitro study of the antimicrobial activity of some endodontic medicaments and their bases using an agar well diffusion assay. Aust. Dent. J. 2009, 54, 141–146. [Google Scholar] [CrossRef]
- Tullio, V.; Mandras, N.; Allizond, V.; Nostro, A.; Roana, J.; Merlino, C.; Banche, G.; Scalas, D.; Cuffini, A.M. Positive interaction of thyme (red) essential oil with human polymorphonuclear granulocytes in eradicating intracellular Candida albicans. Planta Med. 2012, 78, 1633–1635. [Google Scholar] [CrossRef] [PubMed]
- Boukhatem, M.N.; Ferhat, M.A.; Kameli, A.; Saidi, F.; Kebir, H.T. Lemon grass (Cymbopogon citratus) essential oil as a potent anti-inflammatory and antifungal drugs. Libyan J. Med. 2014, 9, 25431. [Google Scholar] [CrossRef] [PubMed]
- de Billerbeck, V.G.; Roques, C.G.; Bessière, J.M.; Fonvieille, J.L.; Dargent, R. Effects of Cymbopogon nardus (L.) W. Watson essential oil on the growth and morphogenesis of Aspergillus niger. Can. J. Microbiol. 2001, 47, 9–17. [Google Scholar] [CrossRef]
- Bansod, S.; Rai, M. Antifungal activity of essential oils from Indian Medicinal plants against human pathogenic Aspergillus fumigatus and A. niger. World J. Med. Sci. 2008, 3, 81–88. [Google Scholar]
- Mandras, N.; Nostro, A.; Roana, J.; Scalas, D.; Banche, G.; Ghisetti, V.; Del Re, S.; Fucale, G.; Cuffini, A.M.; Tullio, V. Liquid and vapour-phase antifungal activities of essential oils against Candida albicans and non-albicans Candida. BMC Complement. Altern. Med. 2016, 16, 330. [Google Scholar] [CrossRef] [PubMed]
- Rajkowska, K.; Nowicka-Krawczyk, P.; Kunicka-Styczyńska, A. Effect of Clove and Thyme Essential Oils on Candida Biofilm Formation and the Oil Distribution in Yeast Cells. Molecules 2019, 24, 1954. [Google Scholar] [CrossRef]
- Shahina, Z.; Molaeitabari, A.; Sultana, T. Cinnamon Leaf and Clove Essential Oils Are Potent Inhibitors of Candida albicans Virulence Traits. Microorganisms 2022, 10, 1989. [Google Scholar] [CrossRef]
- Marchese, A.; Barbieri, R.; Coppo, E.; Orhan, I.E.; Daglia, M.; Nabavi, S.F.; Izadi, M.; Abdollahi, M.; Nabavi, S.M.; Ajami, M. Antimicrobial activity of eugenol and essential oils containing eugenol: A mechanistic viewpoint. Crit. Rev. Microbiol. 2017, 43, 668–689. [Google Scholar] [CrossRef]
- Biernasiuk, A.; Baj, T.; Malm, A. Clove Essential Oil and Its Main Constituent, Eugenol, as Potential Natural Antifungals against Candida spp. Alone or in Combination with Other Antimycotics Due to Synergistic Interactions. Molecules 2022, 28, 215. [Google Scholar] [CrossRef]
- Ju, J.; Xie, Y.; Yu, H.; Guo, Y.; Cheng, Y.; Zhang, R.; Yao, W. Synergistic inhibition effect of citral and eugenol against Aspergillus niger and their application in bread preservation. Food Chem. 2020, 210, 125974. [Google Scholar] [CrossRef]
- Yu, B.; Li, C.; Gu, L.; Zhang, L.; Wang, Q.; Zhang, Y.; Lin, J.; Hu, L.; Jia, Y.; Yin, M.; et al. Eugenol protects against Aspergillus fumigatus keratitis by inhibiting inflammatory response and reducing fungal load. Eur. J. Pharmacol. 2022, 924, 174955. [Google Scholar] [CrossRef] [PubMed]
- Khan, M.S.; Malik, A.; Ahmad, I. Anti-candidal activity of essential oils alone and in combination with amphotericin B or fluconazole against multi-drug resistant isolates of Candida albicans. Med. Mycol. 2012, 50, 33–42. [Google Scholar] [CrossRef] [PubMed]
- Shin, S. Anti-Aspergillus activities of plant essential oils and their combination effects with ketoconazole or amphotericin B. Arch. Pharm. Res. 2003, 26, 389–393. [Google Scholar] [CrossRef] [PubMed]
- Hossain, F.; Follett, P.; Salmieri, S.; Vu, K.D.; Harich, M.; Lacroix, M. Synergistic Effects of Nanocomposite Films Containing Essential Oil Nanoemulsions in Combination with Ionizing Radiation for Control of Rice Weevil Sitophilus oryzae in Stored Grains. J. Food Sci. 2019, 84, 1439–1446. [Google Scholar] [CrossRef] [PubMed]
- Arendrup, M.C.; Cuenca-Estrella, M.; Lass-Flörl, C.; Hope, W. EUCAST technical note on the EUCAST definitive document EDef 7.2: Method for the determination of broth dilution minimum inhibitory concentrations of antifungal agents for yeasts EDef 7.2 (EUCAST-AFST). Clin. Microbiol. Infect. 2012, 18, E246–E247. [Google Scholar] [CrossRef] [PubMed]
- Bedoya-Serna, C.; Dacanal, G.; Fernandes, A.; Pinto, S. Antifungal activity of nanoemulsions encapsulating oregano (Origanum vulgare) essential oil: In vitro study and application in Minas Padrão cheese. Braz. J. Microbiol. 2018, 49, 929–935. [Google Scholar] [CrossRef]
- Carmo, E.; De Oliveira Lima, E.; Souza, E. The potential of Origanum vulgare L. (Lamiaceae) essential oil in inhibiting the growth of some food-related Aspergillus species. Braz. J. Microbiol. 2008, 39, 362–367. [Google Scholar] [CrossRef]
- Hammer, K.A.; Carson, C.F.; Riley, T.V. In vitro activity of Melaleuca alternifolia (tea tree) oil against dermatophytes and other filamentous fungi. J. Antimicrob. Chemother. 2002, 50, 195–199. [Google Scholar] [CrossRef]
- Zuzarte, M.; Salgueiro, L. Essential Oils in Respiratory Mycosis: A Review. Molecules 2022, 27, 4140. [Google Scholar] [CrossRef]
- Berkow, E.L.; Lockhart, S.R.; Ostrosky-Zeichner, L. Antifungal Susceptibility Testing: Current Approaches. Clin. Microbiol. Rev. 2020, 33, e00069-19. [Google Scholar] [CrossRef]
- Magaldi, S.; Mata-Essayag, S.; Hartung de Capriles, C.; Perez, C.; Colella, M.T.; Olaizola, C.; Ontiveros, Y. Well diffusion for antifungal susceptibility testing. Int. J. Infect. Dis. 2004, 8, 39–45. [Google Scholar] [CrossRef]
- Levison, M.E. Pharmacodynamics of antimicrobial drugs. Infect. Dis. Clin. N. Am. 2004, 18, 451–465. [Google Scholar] [CrossRef] [PubMed]
- CLSI. Reference Method for Broth Dilution Antifungal Susceptibility Testing of Filamentous Fungi, 2nd ed.; Approved Standard; CLSI document M38-A2; Clinical and Laboratory Standards Institute: Wayne, PA, USA, 2008; Volume 28, pp. 1–52. [Google Scholar]
- Aimad, A.; Youness, E.A.; Sanae, R.; El Moussaoui, A.; Bourhia, M.; Salamatullah, A.M.; Alzahrani, A.; Alyahya, H.K.; Albadr, N.A.; Nafidi, H.A.; et al. Chemical Composition and Antifungal, Insecticidal and Repellent Activity of Essential Oils From Origanum compactum Benth. Used in the Mediterranean Diet. Front. Plant Sci. 2022, 13, 798259. [Google Scholar] [CrossRef] [PubMed]
- Bueno, J. Models of evaluation of antimicrobial activity of essential oils in vapour phase: A promising use in healthcare decontamination. Nat. Volatiles Essent. Oils 2015, 2, 16–29. [Google Scholar]
- Betts, T.J. Chemical characterisation of the different types of volatile oil constituents by various solute retention ratios with the use of conventional and novel commercial gas chromatographic stationary phases. J. Chromatogr. A 2001, 936, 33–46. [Google Scholar] [CrossRef] [PubMed]
- Pichersky, E.; Noel, J.P.; Dudareva, N. Biosynthesis of plant volatiles: Nature’s diversity and ingenuity. Science 2006, 311, 808–811. [Google Scholar] [CrossRef] [PubMed]

| Family | Scientific Name | Common Name |
|---|---|---|
| Lamiaceae | Lavandula x hybrid | Hybrid lavender |
| Lavandula officinalis P. | Lavender | |
| Origanum vulgare L. | Oregano | |
| Thymus vulgaris L. | Red tRed thyme | |
| Geraniaceae | Pelargonium graveolens L’Hèrin.exAit. | Geranium |
| Myrtaceae | Eugenia caryophyllata Thumb. | Clove |
| Eucalyptus globosus Labill. | Eucalyptus | |
| Melaleuca alternifolia Cheel. | Tea tree | |
| Poaceae | Cymbopogon nardus L. | Lemongrass |
| Rutaceae | Citrus lemon L. | Lemon |
| Citrus aurantium var. bitter L. | Neroli |
| Clinical Strains | MIC µg/mL | MIC EO mg/mL | |||||||||||
|---|---|---|---|---|---|---|---|---|---|---|---|---|---|
| AMB | ITZ | Clove | Eucalyptus | Geranium | Hybrid Lavender | Lavender | |||||||
| A. flavus | AdS 5834 | 8 | >16 | 2.25 | >9 | 2.25 | >9 | >9 | |||||
| A. fumigatus | AdS 5822 | 8 | 16 | 1.12 | >9 | 0.56 | >9 | >9 | |||||
| MOL 4470 | 8 | 16 | 0.56 | >9 | 2.25 | >9 | >9 | ||||||
| MOL 4697 | 8 | 16 | 0.125 | 9 | 4.5 | >9 | 9 | ||||||
| MOL 1517 | 8 | 8 | 0.56 | 9 | 2.25 | >9 | 9 | ||||||
| BEN 177045 | 8 | 8 | 0.56 | >9 | 0.56 | >9 | >9 | ||||||
| MOL 113549 | 4 | 4 | 2.25 | >9 | 2.25 | >9 | >9 | ||||||
| MOL 3628 | 4 | 2 | 1.12 | >9 | 1.12 | >9 | >9 | ||||||
| A. niger | AdS 777 | 4 | 4 | 0.56 | >9 | 0.56 | >9 | >9 | |||||
| MOL 121973 | 2 | 4 | 1.12 | >9 | 1.12 | >9 | >9 | ||||||
| AdS 121822 | 2 | 4 | 0.56 | >9 | 0.56 | >9 | >9 | ||||||
| MOL 5015 | 4 | 2 | 1.12 | >9 | 2.25 | >9 | >9 | ||||||
| AdS 217 | 2 | 2 | 2.25 | >9 | 2.25 | >9 | >9 | ||||||
| Clinical Strains | MIC EO mg/mL | ||||||||||||
| Lemon | Lemongrass | Neroli | Oregano | Tea tree | Red thyme | ||||||||
| A. flavus | AdS 5834 | >9 | 0.56 | >9 | 4.5 | 9 | >9 | ||||||
| A. fumigatus | AdS 5822 | 2.25 | 0.56 | >9 | >9 | 4.5 | 4.5 | ||||||
| MOL 4470 | 2.25 | 0.56 | >9 | >9 | 4.5 | >9 | |||||||
| MOL 4697 | >9 | 0.56 | >9 | >9 | 4.5 | >9 | |||||||
| MOL 1517 | 2.25 | 0.56 | >9 | >9 | 4.5 | 9 | |||||||
| BEN 177045 | 2.25 | 0.56 | >9 | >9 | 4.5 | 9 | |||||||
| MOL 113549 | 4.5 | 1.12 | >9 | >9 | 4.5 | >9 | |||||||
| MOL 3628 | 2.25 | 1.12 | >9 | >9 | 4.5 | >9 | |||||||
| A. niger | AdS 777 | 2.25 | 1.12 | >9 | >9 | >9 | >9 | ||||||
| MOL 121973 | 2.25 | 1.12 | >9 | >9 | >9 | >9 | |||||||
| AdS 121822 | 2.25 | 0.56 | >9 | >9 | >9 | >9 | |||||||
| MOL 5015 | 1.12 | 1.12 | >9 | >9 | >9 | >9 | |||||||
| AdS 217 | 4.5 | 1.12 | >9 | >9 | >9 | >9 | |||||||
| Clinical Strains | MFC µg/mL | MFC EO mg/mL | ||||
|---|---|---|---|---|---|---|
| AMB | ITZ | Clove | Geranium | Lemongrass | ||
| A. flavus | AdS 5834 | >16 | >16 | 4.5 | 4.5 | 2.25 |
| A. fumigatus | AdS 5822 | 8 | 16 | 4.5 | 2.25 | 2.25 |
| MOL 4470 | 8 | 16 | 2.25 | 2.25 | 4.5 | |
| MOL 4697 | 8 | >16 | 4.5 | 4.5 | 4.5 | |
| MOL 1517 | 8 | 8 | 4.5 | 1.12 | 4.5 | |
| BEN 177045 | 8 | 8 | 4.5 | 1.12 | 2.25 | |
| MOL 113549 | 4 | 4 | 4.5 | 2.25 | 4.5 | |
| MOL 3628 | 4 | 2 | 4.5 | 2.25 | 4.5 | |
| A. niger | AdS 777 | 4 | 4 | 9 | 2.25 | 2.25 |
| MOL 121973 | 2 | 4 | 9 | 2.25 | 2.25 | |
| AdS 121822 | 2 | 4 | 9 | 4.5 | 2.25 | |
| MOL 5015 | 4 | 2 | 9 | 4.5 | 4.5 | |
| AdS 217 | 2 | 2 | 9 | 2.25 | 4.5 | |
| Clinical Strains | Disc-Diffusion Assay (mm) | ||||||||
|---|---|---|---|---|---|---|---|---|---|
| AMB | ITZ | Clove | Geranium | Lemongrass | |||||
| 20 µg | 10 µg | 50 µg | 150 µg | 50 µg | 150 µg | 50 µg | 150 µg | ||
| A. flavus | AdS 5834 | 10 ± 0.1 | 14 ± 0.0 | 30 ± 0.0 | 66 ± 0.2 a | 13 ± 0.5 c | 22 ± 0.0 c | 12 ± 0.0 c | 21 ± 0.0 |
| A. fumigatus | AdS 5822 | 12 ± 0.5 | - | 38 ± 0.2 | 42 ± 0.2 a | 12 ± 0.2 c | 40 ± 0.1 c | 13 ± 0.0 c | 38 ± 0.1 |
| BEN 177045 | 12 ± 0.1 | 25 ± 0.2 | 50 ± 0.1 | 55 ± 0.5 a | 29 ± 0.1 | 45 ± 0.0 | 14 ± 0.1 | 32 ± 0.0 | |
| MOL 113549 | 11 ± 0.0 | 21 ± 0.1 | 29 ± 0.1 | 42 ± 0.0 a | 16 ± 0.0 | 25 ± 0.0 | 21 ± 0.2 | 51 ± 0.0 | |
| MOL 3628 | - | 17 ± 0.0 | 26 ± 0.2 | 39 ± 0.0 | 14 ± 0.0 | 42 ± 0.4 | 19 ± 0.1 | 35 ± 0.1 | |
| A. niger | AdS 777 | 13 ± 0.0 | 14 ± 0.4 | 35 ± 0.4 | 56± 0.1 ab | 10 ± 0.0 c | 22 ± 0.6 c | - | 45 ± 0.2 |
| MOL 121973 | 12 ± 0.1 | 11 ± 0.1 | 29 ± 0.3 | 42 ± 0.0 ab | - | 16 ± 0.1 c | - | 20 ± 0.0 | |
| AdS 121822 | - | - | 27 ± 0.0 | 43 ± 0.3 | - | 15 ± 0.0 c | - | 14 ± 0.4 | |
Disclaimer/Publisher’s Note: The statements, opinions and data contained in all publications are solely those of the individual author(s) and contributor(s) and not of MDPI and/or the editor(s). MDPI and/or the editor(s) disclaim responsibility for any injury to people or property resulting from any ideas, methods, instructions or products referred to in the content. |
© 2023 by the authors. Licensee MDPI, Basel, Switzerland. This article is an open access article distributed under the terms and conditions of the Creative Commons Attribution (CC BY) license (https://creativecommons.org/licenses/by/4.0/).
Share and Cite
Allizond, V.; Cavallo, L.; Roana, J.; Mandras, N.; Cuffini, A.M.; Tullio, V.; Banche, G. In Vitro Antifungal Activity of Selected Essential Oils against Drug-Resistant Clinical Aspergillus spp. Strains. Molecules 2023, 28, 7259. https://doi.org/10.3390/molecules28217259
Allizond V, Cavallo L, Roana J, Mandras N, Cuffini AM, Tullio V, Banche G. In Vitro Antifungal Activity of Selected Essential Oils against Drug-Resistant Clinical Aspergillus spp. Strains. Molecules. 2023; 28(21):7259. https://doi.org/10.3390/molecules28217259
Chicago/Turabian StyleAllizond, Valeria, Lorenza Cavallo, Janira Roana, Narcisa Mandras, Anna Maria Cuffini, Vivian Tullio, and Giuliana Banche. 2023. "In Vitro Antifungal Activity of Selected Essential Oils against Drug-Resistant Clinical Aspergillus spp. Strains" Molecules 28, no. 21: 7259. https://doi.org/10.3390/molecules28217259
APA StyleAllizond, V., Cavallo, L., Roana, J., Mandras, N., Cuffini, A. M., Tullio, V., & Banche, G. (2023). In Vitro Antifungal Activity of Selected Essential Oils against Drug-Resistant Clinical Aspergillus spp. Strains. Molecules, 28(21), 7259. https://doi.org/10.3390/molecules28217259

